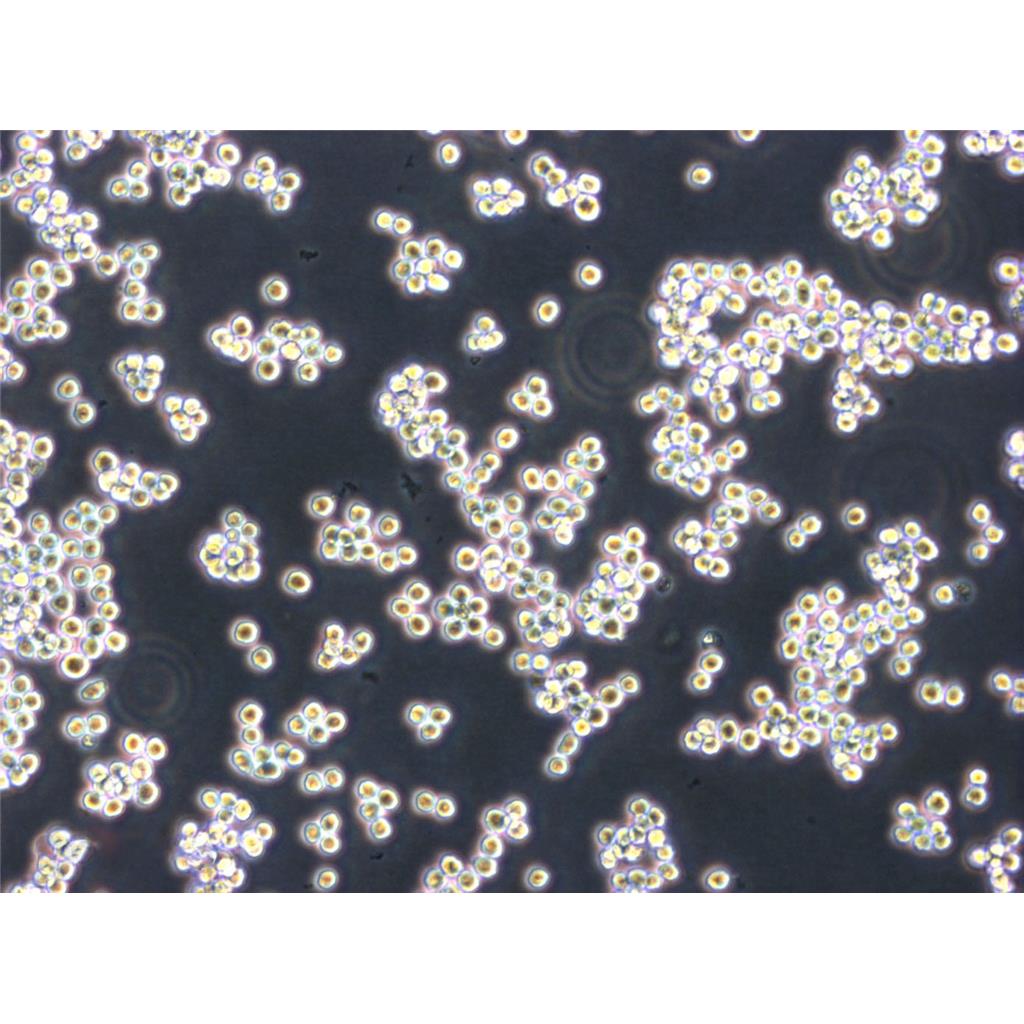
CAL-33 Cells人舌鳞癌贴壁细胞系(提供所有细胞STR鉴定图谱)

"CAL-33 Cells人舌鳞癌贴壁细胞系(提供所有细胞STR鉴定图谱)
传代比例:1:2-1:4(首次传代建议1:2)
背景信息:详见相关文献介绍
┈订┈购(技术服务)┈热┈线:1┈3┈6┈4┈1┈9┈3┈0┈7┈9┈1【微信同号】┈Q┈Q:3┈1┈8┈0┈8┈0┈7┈3┈2┈4;
Panc-10.05 Cells;背景说明:详见相关文献介绍;传代方法:1:2传代;生长特性:贴壁生长;形态特性:上皮样;相关产品有:OVCA432_Bast细胞、GP2-293细胞、Rat1细胞
UCLA SO M21 Cells;背景说明:黑色素瘤;女性;传代方法:1:2-1:3传代;每周换液2-3次。;生长特性:贴壁;形态特性:详见产品说明书;相关产品有:MAVER-1细胞、Mono Mac 6细胞、SF-295细胞
V79-1 Cells;背景说明:肺;自发永生;雄性;传代方法:1:2-1:3传代;每周换液2-3次。;生长特性:贴壁;形态特性:详见产品说明书;相关产品有:MM96L细胞、Capan1细胞、HEY-A8细胞
CAL 62 Cells;背景说明:详见相关文献介绍;传代方法:1:2-1:3传代;每周换液2-3次。;生长特性:贴壁或悬浮,详见产品说明书部分;形态特性:详见产品说明书;相关产品有:NTC200细胞、TB1 Lu细胞、SP2-0-Ag14细胞
换液周期:每周2-3次
细胞常规培养传代流程(请严格遵照无菌操作):1)吸出原培养瓶中的培养基,PBS缓冲润洗细胞两次,加2-3ml 0.25%胰酶进行消化细胞(注意把握消化时间,通常控制在1-2min);2)镜下观察消化情况,在细胞边缘缩小,贴壁松动时(不建议消化到细胞漂浮)去掉胰酶,加6-8ml完全培养基,轻轻吹打细胞层,尽量把细胞层吹落,吹散;3)取部分细胞悬转移到新的培养皿/瓶中,添加适当的完全培养基,把细胞悬打匀,于培养箱中培养;4)注意培养基PH值变化情况,定期换(每周2-3次),待细胞密度达到80%以后重复1项操作或者冻存;别注意:(如使用公共实验室或者初次接触细胞培养,建议添加双抗培养)1)收到细胞后请尽快更换为含15%血清的新鲜培养基,如因殊情况需要继续使用原瓶,请在原瓶培养基中额外添加10%的血清,(原瓶培养基的继续使用时间Zui长不宜超过72小时);2)贴壁细胞收到当天切忌立刻消化,请将细胞换后放置培养箱孵育到第二天再做消化传代,请YOU先选择直径6cm的培养皿进行传代培养;3)如签收时出现培养瓶壁破裂,漏等情况请及时做HAO照片记录并联系实验室。
CAL-33 Cells人舌鳞癌贴壁细胞系(提供所有细胞STR鉴定图谱)
生长特性:贴壁生长
产品包装:复苏发货:T25培养瓶(一瓶)或冻存发货:1ml冻存管(两支)
102PT Cells;背景说明:乳腺癌;女性;传代方法:1:2-1:3传代;每周换液2-3次。;生长特性:贴壁;形态特性:详见产品说明书;相关产品有:KMH2细胞、COLO 16细胞、C2C12细胞
KP2 Cells;背景说明:胰腺癌;女性;传代方法:1:2-1:3传代;每周换液2-3次。;生长特性:贴壁;形态特性:详见产品说明书;相关产品有:Hs832.Tc细胞、PAa细胞、NRCC细胞
VMRCLCD Cells;背景说明:详见相关文献介绍;传代方法:1:2-1:3传代;每周换液2-3次。;生长特性:贴壁或悬浮,详见产品说明书部分;形态特性:详见产品说明书;相关产品有:L-5178-Y-R细胞、PaTu-8988s细胞、Astrocyte type I clone细胞
Huh 7.5 Cells;背景说明:肝癌;男性;传代方法:1:2-1:3传代;每周换液2-3次。;生长特性:贴壁;形态特性:详见产品说明书;相关产品有:MiaPaCa2细胞、Lewis Lung Cancer细胞、SUM 190细胞
┈订┈购(技术服务)┈热┈线:1┈3┈6┈4┈1┈9┈3┈0┈7┈9┈1【微信同号】┈Q┈Q:3┈1┈8┈0┈8┈0┈7┈3┈2┈4;
来源说明:细胞主要来源ATCC、ECACC、DSMZ、RIKEN等细胞库
【细胞培养中支原体、黑蛟虫、真菌的污染情况总结】支原体:黑色的,HAO象多为多形,培养一般培养一般会浑浊,原体感染,国内血清很多都没有做支原体阴性检测,而支原体是牛血清中Zui常见的微生物之一。而且它不能用过滤的办法除去。支原体感染细胞以后,细胞病变不很明显,只是慢慢死去。用泰乐菌素,兽用支原体病的药,但可用于细胞培养,无任何不良反应。如果作为常用的抗生素的话, 建议用8ug/ml的浓度;黑蛟虫:可以穿透滤膜,也可以通过空气传播,低倍下为黑色点状,GAO倍下可看见黑色的小虫游来游去,培养也是不浑的,一般不会太影响,细胞还是可以用的。常常是细胞生长状态良HAO,且观测到的运动物无明显增多,且培养颜色、透明度无明显变化,可在同一批号的血清养的细胞中发现类似现象。对细胞生长状态不会有明显影响,在细胞增殖旺盛之后会自然消失,除更换血清外无须殊处理。建议如果细胞有可能是此种污染的话,可以增加细胞的种板密度,以提GAO细胞的生存率;真菌:一般培养清亮,不变色,镜下有丝状物,有些真菌开始很像死细胞碎片,只是它很多很多的小块很清楚,象珊瑚状,不象细胞碎片分不清,慢慢的会长出很细的黑色丝状物。真菌生长的比较慢,不象细菌那么容易被发现,但是一旦发现有它的存在细胞就被污染了,也很难救活了。
物种来源:人源、鼠源等其它物种来源
CAL-33 Cells人舌鳞癌贴壁细胞系(提供所有细胞STR鉴定图谱)
形态特性:上皮细胞样
在实验室细胞培养过程中,细胞聚集是一个常见的问题,它可能会影响细胞的正常生长、实验结果的准确性等诸多方面。为了防止细胞聚集,科研人员通常会采用多种有效的方法。首先,合适的细胞培养容器表面处理至关重要。许多细胞培养瓶和培养皿会经过特殊的表面处理,例如用亲水性的聚合物涂层。减少细胞之间因为吸附在同一位置而聚集的可能性。酶处理也是常用的手段之一。在细胞消化传代过程中,使用适量的胰蛋白酶等酶试剂。胰蛋白酶能够分解细胞间的连接蛋白,使细胞彼此分离。但是,酶的浓度和处理时间需要严格把控。如果酶浓度过高或者处理时间过长,虽然细胞能够很好地分散,但可能会对细胞造成损伤,影响细胞的活性。以常见的哺乳动物细胞为例,一般使用0.25%的胰蛋白酶,在37℃下处理1-3分钟,就可以有效地将细胞分散开,同时又能保证细胞的健康状态。添加合适的试剂也是防止细胞聚集的有效策略。一些抗聚集剂如乙二胺四乙酸(EDTA)被广泛使用。EDTA能够螯合细胞培养液中的钙、镁离子,而这些离子是细胞间连接所依赖的重要成分。当它们被螯合后,细胞间的连接就会变弱,从而减少聚集。在细胞培养过程中,轻柔的操作也不容忽视。无论是在细胞的接种、换液还是转移过程中,避免剧烈摇晃或吹打。通过这些综合的方法,实验室能够更好地防止细胞聚集,为细胞系培养实验的成功提供保障。
Abcam HCT 116 ANO1 KO Cells(提供STR鉴定图谱)
AG04357 Cells(提供STR鉴定图谱)
BayGenomics ES cell line CSI075 Cells(提供STR鉴定图谱)
BayGenomics ES cell line RST279 Cells(提供STR鉴定图谱)
BeWo b30 Cells(提供STR鉴定图谱)
CHO/IDH2-R172S Cells(提供STR鉴定图谱)
DA02995 Cells(提供STR鉴定图谱)
EL4.BU.1.OUAr.1.1 Cells(提供STR鉴定图谱)
GM05848 Cells(提供STR鉴定图谱)
LWnt3A Cells;背景说明:详见相关文献介绍;传代方法:1:2-1:3传代;每周换液2-3次。;生长特性:贴壁或悬浮,详见产品说明书部分;形态特性:详见产品说明书;相关产品有:NCI-H2195细胞、NCI-H2330细胞、SGC-7901细胞
HFTF Cells;背景说明:胚胎;眼;成纤维 Cells;传代方法:1:2-1:3传代;每周换液2-3次。;生长特性:贴壁;形态特性:详见产品说明书;相关产品有:HeLa细胞、AX-Mel细胞、NCIH1048细胞
H498 Cells;背景说明:结肠腺癌;男性;传代方法:1:2-1:3传代;每周换液2-3次。;生长特性:半贴壁;形态特性:详见产品说明书;相关产品有:MES-23.5细胞、NCI-H676细胞、Mel-MeWo细胞
D341Med Cells;背景说明:详见相关文献介绍;传代方法:每周换液2-3次。;生长特性:悬浮生长;形态特性:髓母细胞样;相关产品有:NCI-H2405细胞、U20S细胞、MDA-MB-157细胞
Hs695T Cells;背景说明:详见相关文献介绍;传代方法:1:2-1:4传代,2-3天换液1次。;生长特性:贴壁生长;形态特性:上皮细胞;相关产品有:Rat Basophilic Leukemia-1细胞、COLO320/DM细胞、SUPM2细胞
Opossum Kidney Cells;背景说明:肾;传代方法:1:2-1:3传代;每周换液2-3次。;生长特性:贴壁;形态特性:详见产品说明书;相关产品有:SK RC 52细胞、Stanford University-Diffuse Histiocytic Lymphoma-1细胞、NHA细胞
GL261 Cells;背景说明:详见相关文献介绍;传代方法:1:2-1:3传代;每周换液2-3次。;生长特性:贴壁;形态特性:上皮细胞样;相关产品有:GM02131细胞、SK-N-MC细胞、HuH-1细胞
Colon26 Cells;背景说明:详见相关文献介绍;传代方法:1:2-1:3传代;每周换液2-3次。;生长特性:贴壁或悬浮,详见产品说明书部分;形态特性:详见产品说明书;相关产品有:ABE8.1/2细胞、TE 85.T细胞、BCECs细胞
NCI-H1437 Cells;背景说明:详见相关文献介绍;传代方法:1:2-1:6传代,每周换液2次。;生长特性:贴壁生长;形态特性:上皮样;相关产品有:H2141细胞、MV 3细胞、KBM-7/Hap8细胞
NCIH747 Cells;背景说明:详见相关文献介绍;传代方法:1:2—1:4传代,每周换液2次;生长特性:贴壁生长;形态特性:上皮样;相关产品有:SK Mel 1细胞、RFL-6细胞、U266BL细胞
JOSK-M Cells;背景说明:急性单核细胞白血病;男性;传代方法:1:2-1:3传代;每周换液2-3次。;生长特性:悬浮;形态特性:详见产品说明书;相关产品有:SKNO-1细胞、Colo699细胞、HcaF细胞
HCC-4006 Cells;背景说明:详见相关文献介绍;传代方法:1:4-1:6传代,每周2-3次。;生长特性:贴壁生长;形态特性:上皮细胞样;相关产品有:SNU869细胞、H-841细胞、Suzhou Human Glioma-44细胞
MV-4-11 Cells;背景说明:详见相关文献介绍;传代方法:1:2-1:3传代;每周换液2-3次。;生长特性:贴壁或悬浮,详见产品说明书部分;形态特性:详见产品说明书;相关产品有:OCILY-3细胞、SPC-A1细胞、UACC-893细胞
L-929 Cells;背景说明:详见相关文献介绍;传代方法:1:2-1:3传代;每周换液2-3次。;生长特性:贴壁或悬浮,详见产品说明书部分;形态特性:详见产品说明书;相关产品有:SN12PM6细胞、HANK-1细胞、Hs.27细胞
COLO206 Cells;背景说明:详见相关文献介绍;传代方法:1:2-1:3传代;每周换液2-3次。;生长特性:贴壁或悬浮,详见产品说明书部分;形态特性:详见产品说明书;相关产品有:NALM-6-M1细胞、H-II-E-C3细胞、SU-DHL-16细胞
HEMCSS Cells;背景说明:详见相关文献介绍;传代方法:1:4-1:8传代;每周换液3次。;生长特性:贴壁生长;形态特性:详见产品说明书;相关产品有:STTG1细胞、SKCO 1细胞、RL95细胞
HEMCSS Cells;背景说明:详见相关文献介绍;传代方法:1:4-1:8传代;每周换液3次。;生长特性:贴壁生长;形态特性:详见产品说明书;相关产品有:STTG1细胞、SKCO 1细胞、RL95细胞
CAL-33 Cells人舌鳞癌贴壁细胞系(提供所有细胞STR鉴定图谱)
H-2172 Cells;背景说明:详见相关文献介绍;传代方法:1:3-1:6传代;每周换液2-3次。;生长特性:贴壁生长;形态特性:详见产品说明书;相关产品有:B16-F10--RED细胞、H341细胞、GM04671细胞
OCI-AML-5 Cells;背景说明:急性髓系白血病细胞;男性;传代方法:1:2-1:3传代;每周换液2-3次。;生长特性:悬浮;形态特性:详见产品说明书;相关产品有:SNU398细胞、16HBE细胞、SK-N-BE(2C)细胞
F-36P Cells;背景说明:详见相关文献介绍;传代方法:每周2次换液;生长特性:贴壁或悬浮,详见产品说明书部分;形态特性:详见产品说明书;相关产品有:Hepa 1-6细胞、NB9细胞、PLMVEC细胞
GM03190A Cells;背景说明:1967年,该细胞系KleinE和KleinG建系,源于一名16岁患有Burkitt's淋巴瘤的黑人男性,beta-2-微球蛋白阴性,表达EBNA,VCA,sIg。该细胞携带EB病毒,是一个典型的B淋巴母细胞系,可用于白血病发病机制的研究。;传代方法:1:2传代;生长特性:悬浮生长;形态特性:淋巴母细胞样;相关产品有:A-253细胞、Fu97细胞、TEC细胞
LAD 2 Cells;背景说明:肥大 Cells;传代方法:1:2-1:3传代;每周换液2-3次。;生长特性:悬浮;形态特性:详见产品说明书;相关产品有:GC-1细胞、SN4741细胞、Hs 746T细胞
PL45 Cells;背景说明:详见相关文献介绍;传代方法:1:2传代;生长特性:贴壁生长;形态特性:上皮样;相关产品有:4T1细胞、NHDF细胞、Centre Antoine Lacassagne-12T细胞
┈订┈购(技术服务)┈热┈线:1┈3┈6┈4┈1┈9┈3┈0┈7┈9┈1【微信同号】┈Q┈Q:3┈1┈8┈0┈8┈0┈7┈3┈2┈4;
HCC1143 Cells;背景说明:详见相关文献介绍;传代方法:1:2—1:4传代,每周换液2—3次;生长特性:贴壁生长;形态特性:上皮样;相关产品有:Biopsy xenograft of Pancreatic Carcinoma line-3细胞、NL-20细胞、MDCK-II细胞
Kasumi-1 Cells;背景说明:详见相关文献介绍;传代方法:1:2传代。3天内可长满。;生长特性:悬浮生长;形态特性:原粒细胞;相关产品有:NCIH1623细胞、HL-60 Clone 15细胞、NCI-H1155细胞
Jurkat clone A3 Cells;背景说明:详见相关文献介绍;传代方法:1:2-1:3传代;每周换液2-3次。;生长特性:贴壁或悬浮,详见产品说明书部分;形态特性:详见产品说明书;相关产品有:LL/2 (LLC1)细胞、RTMC细胞、RIN m5F细胞
H2171 Cells;背景说明:详见相关文献介绍;传代方法:3-4天换液1次。;生长特性:悬浮生长;形态特性:聚团悬浮;相关产品有:LS513细胞、293T/17细胞、HSC-4细胞
Colon38 Cells;背景说明:详见相关文献介绍;传代方法:1:2传代;生长特性:贴壁生长;形态特性:上皮细胞样;相关产品有:H125细胞、RC13细胞、JF305细胞
EVSAT Cells;背景说明:乳腺癌;腹水转移;女性;传代方法:1:2-1:3传代;每周换液2-3次。;生长特性:贴壁;形态特性:详见产品说明书;相关产品有:MB49细胞、HCC0044细胞、PVEC细胞
GM50063 Cells(提供STR鉴定图谱)
HAP1 PHF6 (-) 2 Cells(提供STR鉴定图谱)
HEV0151 Cells(提供STR鉴定图谱)
HSC-F Cells(提供STR鉴定图谱)
KOLF2.1J TH-TdTomato Cells(提供STR鉴定图谱)
MonoTCC Cells(提供STR鉴定图谱)
NYSCF-10005-1081-1081-Skin-mR-iPS Cells(提供STR鉴定图谱)
RG-403 Cells(提供STR鉴定图谱)
SU-DHL-4/12V Cells(提供STR鉴定图谱)
Ubigene HeLa COL4A5 KO Cells(提供STR鉴定图谱)
WTC-mTagRFPT-CETN2-cl19 Cells(提供STR鉴定图谱)
A9(Neo8) Cells(提供STR鉴定图谱)
EST50 Cells;背景说明:详见相关文献介绍;传代方法:1:3-1:5传代,2-3天换液1次。;生长特性:混合生长;形态特性:成纤维细胞;相关产品有:CCD-1095Sk细胞、GLRK 13细胞、SKES1细胞
PC-3M IE8 Cells;背景说明:前列腺癌;男性;传代方法:1:2-1:3传代;每周换液2-3次。;生长特性:贴壁;形态特性:详见产品说明书;相关产品有:Vertebral Cancer of the Prostate细胞、MRC-V细胞、AML-12细胞
SKGIIIA Cells;背景说明:详见相关文献介绍;传代方法:2x10^4 cells/ml;生长特性:贴壁生长;形态特性:上皮细胞样;相关产品有:Strain L-929细胞、MDAMB415细胞、H1672细胞
D407 Cells;背景说明:详见相关文献介绍;传代方法:1:2传代;生长特性:贴壁生长 ;形态特性:详见产品说明书;相关产品有:NIH:OVCAR-3细胞、IB-RS-2细胞、Panc5.04细胞
7404 Cells;背景说明:用Northernblot方法,未能检测到细胞中1.3kbLFIRE-1/HFREP-1mRNA的表达。;传代方法:消化3-5分钟。1:2。3天内可长满。;生长特性:贴壁生长;形态特性:上皮细胞样;相关产品有:4-1st细胞、Hs 706.T细胞、Hs 821.T细胞
LC-1/sq Cells;背景说明:详见相关文献介绍;传代方法:1:2-1:3传代;每周换液2-3次。;生长特性:贴壁或悬浮,详见产品说明书部分;形态特性:详见产品说明书;相关产品有:Panc 10.05细胞、Scott细胞、EC-GI细胞
Fetal Human Lens-124 Cells;背景说明:晶状体上皮;自发永生;传代方法:1:2-1:3传代;每周换液2-3次。;生长特性:贴壁;形态特性:详见产品说明书;相关产品有:bEnd.3[BEND3]细胞、A375-S2细胞、A-431细胞
MEL-526 Cells;背景说明:黑色素瘤;传代方法:1:2-1:3传代;每周换液2-3次。;生长特性:贴壁;形态特性:详见产品说明书;相关产品有:Tj-905细胞、HEK 293-H细胞、WILL2细胞
hTERT-HPNE Cells;背景说明:胰腺导管;HGNC-TERT转化;男性;传代方法:1:2-1:3传代;每周换液2-3次。;生长特性:贴壁;形态特性:详见产品说明书;相关产品有:OVCAR-8/ADR细胞、LUDLU1细胞、Lewis lung carcinoma细胞
TOV21G Cells;背景说明:详见相关文献介绍;传代方法:1:3-1:4传代,3-4天换液1次。;生长特性:贴壁生长;形态特性:上皮细胞;相关产品有:Ontario Cancer Institute-Acute Myeloid Leukemia-4细胞、PANC-1细胞、SNU398细胞
C-33-A Cells;背景说明:C-33A细胞株是N. Auersperg从宫颈癌切片中建立的一系列细胞株(参见ATCC CRL-1594和ATCC CRL-1595)中的一株。 细胞一开始就表现出亚二倍体核型及上皮细胞形态。 连续传代可以观察到核型不稳定。 存在成视网膜细胞瘤蛋白(pRB),但大小不正常。 P53表达上调,且有一个273位密码子的点突变导致Arg -> Cys的替换。 人乳头瘤病毒DNA及RNA阴性。;传代方法:1:2传代;生长特性:贴壁生长;形态特性:上皮细胞样;相关产品有:PVEC细胞、293c18细胞、NCI-H2107细胞
RPMI1788 Cells;背景说明:B淋巴细胞;EBV转化;传代方法:1:2-1:3传代;每周换液2-3次。;生长特性:悬浮;形态特性:详见产品说明书;相关产品有:NCI-H1436细胞、UM-UC14细胞、NCI-H1436细胞
GM04679 Cells;背景说明:该细胞源自一名3岁患有Burkitt's淋巴瘤的黑人男孩的B淋巴细胞,EBNA阳性。;传代方法:1:2-1:4传代,每周2-3次。;生长特性:悬浮生长;形态特性:淋巴母细胞样;相关产品有:HEK-2细胞、CO115细胞、SK-RC-42细胞
PL5 Cells;背景说明:详见相关文献介绍;传代方法:1:2传代;生长特性:贴壁生长;形态特性:上皮样;相关产品有:PSN-1细胞、JM-Jurkat细胞、SK-N-FI细胞
NCI-HUT-292 Cells;背景说明:详见相关文献介绍;传代方法:1:3-1:8传代;2-3天换液1次。;生长特性:贴壁生长;形态特性:上皮样;相关产品有:NCIH2291细胞、H322T细胞、SUDHL4细胞
MDCK Type II Cells;背景说明:详见相关文献介绍;传代方法:1:3传代,3-4天传1次;生长特性:贴壁生长;形态特性:上皮样;相关产品有:LMH细胞、Michigan Cancer Foundation-12F细胞、HEC-1A细胞
SVG(P12) Cells;背景说明:星形胶质细胞;SV40转化;男性;传代方法:1:2-1:3传代;每周换液2-3次。;生长特性:贴壁;形态特性:详见产品说明书;相关产品有:BPH1细胞、NCI-SNU-886细胞、COLO320-DM细胞
PLC-8024 Cells;背景说明:该细胞系分泌乙肝病毒表面抗原(HBsAg)。 此细胞系原先被支原体污染,后用BM-cycline去除支原体;传代方法:1:2传代;生长特性:贴壁生长;形态特性:上皮样;相关产品有:aTC1-6细胞、BT-B细胞、AMC-HN8细胞
D10 Cells;背景说明:T淋巴细胞;AKR/J;传代方法:1:2-1:3传代;每周换液2-3次。;生长特性:悬浮;形态特性:详见产品说明书;相关产品有:HDLM2细胞、ACC-2细胞、AAV293细胞
WSU-DLCL2 Cells;背景说明:弥漫大B淋巴瘤;男性;传代方法:1:2-1:3传代;每周换液2-3次。;生长特性:悬浮;形态特性:详见产品说明书;相关产品有:RL-95-2细胞、MIO-M1细胞、CEM/C1细胞
HCC1954 Cells;背景说明:详见相关文献介绍;传代方法:1:4-1:8传代;每周换液2-3次。;生长特性:偶尔上皮细胞空泡;形态特性:上皮细胞样;相关产品有:MFE280细胞、A549-Taxol细胞、SKO3细胞
BC-022 Cells;背景说明:详见相关文献介绍;传代方法:1:2-1:3传代;每周换液2-3次。;生长特性:贴壁或悬浮,详见产品说明书部分;形态特性:详见产品说明书;相关产品有:EL-4细胞、COLO 206F细胞、RPMI-7666细胞
Buffalo Rat Liver-3A Cells;背景说明:详见相关文献介绍;传代方法:1:2-1:3传代;每周换液2-3次。;生长特性:贴壁或悬浮,详见产品说明书部分;形态特性:详见产品说明书;相关产品有:VMRCLCD细胞、Hs940.T细胞、Verda reno细胞
HCa/16A3-F Cells;背景说明:肝癌;传代方法:1:2-1:3传代;每周换液2-3次。;生长特性:贴壁;形态特性:详见产品说明书;相关产品有:SHEP1细胞、CCK-81细胞、RA.1细胞
OCILY19 Cells;背景说明:弥漫大B淋巴瘤;女性;传代方法:1:2-1:3传代;每周换液2-3次。;生长特性:悬浮;形态特性:详见产品说明书;相关产品有:hFOB 1.19细胞、NCIH2029细胞、Walker-256细胞
OCIAML4 Cells;背景说明:急性髓系白血病;女性;传代方法:1:2-1:3传代;每周换液2-3次。;生长特性:悬浮;形态特性:详见产品说明书;相关产品有:NG10815细胞、A2780/Taxol细胞、3T3 clone A31细胞
C-4 I Cells;背景说明:宫颈鳞癌;女性;传代方法:1:2-1:3传代;每周换液2-3次。;生长特性:贴壁;形态特性:详见产品说明书;相关产品有:Wills Eye Research Institute-Retinoblastoma-1细胞、THP-1(ATCC)细胞、CCRF/CEM细胞
CAL-33 Cells人舌鳞癌贴壁细胞系(提供所有细胞STR鉴定图谱)
Leydig Cells;背景说明:睾丸;间质 Cells;传代方法:1:2-1:3传代;每周换液2-3次。;生长特性:贴壁;形态特性:详见产品说明书;相关产品有:CTSC-3细胞、BPH-1细胞、MC3T3-L1细胞
MEC1 Cells;背景说明:粘液表皮样癌;传代方法:1:2-1:3传代;每周换液2-3次。;生长特性:贴壁;形态特性:详见产品说明书;相关产品有:J 111细胞、Rat Chondrosarcoma Swarm细胞、SK Col 1细胞
C-Lu65 Cells;背景说明:详见相关文献介绍;传代方法:1:10传代;生长特性:贴壁生长;形态特性:成纤维细胞;相关产品有:MOLP-2细胞、RCC10细胞、NCIH2009细胞
KYSE 30 Cells;背景说明:来源于一位64岁,患有高分化的中段食管鳞癌的男性患者。;传代方法:1:2-1:3传代;每周换液2-3次。;生长特性:贴壁;形态特性:上皮细胞样;相关产品有:P3HR1细胞、EA.Hy926细胞、PCI-04B细胞
D407 RPE Cells;背景说明:详见相关文献介绍;传代方法:1:2传代;生长特性:贴壁生长 ;形态特性:详见产品说明书;相关产品有:NCI H508细胞、SuDHL 10细胞、GM05384细胞
Clone Y1 Cells;背景说明:详见相关文献介绍;传代方法:1:2-1:3传代;每周换液2-3次。;生长特性:贴壁或悬浮,详见产品说明书部分;形态特性:详见产品说明书;相关产品有:COR-L23/P细胞、RPE1-hTERT细胞、H1876细胞
AN3CA Cells;背景说明:AN3CA细胞建系于1964年。它衍生于子宫内膜癌患者淋巴结转移组织,具有癌细胞的基本特性,能在体外长期传代培养,接种实验动物产生明显肿瘤。但细胞的生物学特性及超微结构尚未深入研究,仅发现该细胞系促黑激素合成为阴性。细胞常用于人子宫内膜癌细胞生物学及其相关特性研究。;传代方法:1:2传代;生长特性:贴壁生长;形态特性:上皮样;相关产品有:MB 157细胞、M-G63细胞、CHO-K1细胞
TE-32 Cells;背景说明:详见相关文献介绍;传代方法:1:2-1:4传代,3-4天换液1次。;生长特性:贴壁生长;形态特性:梭型和大的多核细胞;相关产品有:P3-Jiyoye细胞、Hepatoma 22细胞、IPEC-1细胞
┈订┈购(技术服务)┈热┈线:1┈3┈6┈4┈1┈9┈3┈0┈7┈9┈1【微信同号】┈Q┈Q:3┈1┈8┈0┈8┈0┈7┈3┈2┈4;
CMT93 Cells;背景说明:结肠癌;C57BL/ICRF;传代方法:1:2-1:3传代;每周换液2-3次。;生长特性:贴壁;形态特性:详见产品说明书;相关产品有:SK-MEL-2细胞、NCI-H719细胞、NCI-H1975细胞
LN-18 Cells;背景说明:详见相关文献介绍;传代方法:1:4-1:6传代;每周换液2-3次;生长特性:贴壁生长;形态特性:上皮细胞;相关产品有:SPC-A-1细胞、SK-RC-39细胞、GRSL细胞
MIN-6 Cells;背景说明:详见相关文献介绍;传代方法:1:2传代;生长特性:贴壁生长;形态特性:详见产品说明书;相关产品有:TE-9细胞、SVG p12细胞、NS1/1-Ag4.1细胞
BayGenomics ES cell line RRJ603 Cells(提供STR鉴定图谱)
BayGenomics ES cell line XK584 Cells(提供STR鉴定图谱)
G1E-ER4 Cells(提供STR鉴定图谱)
NR1 Cells(提供STR鉴定图谱)
XMMPS-OP1 Cells(提供STR鉴定图谱)
MCH051 Cells(提供STR鉴定图谱)
"